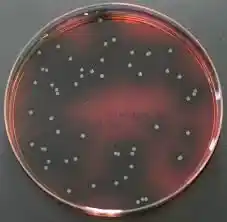
خرید محیط کشت پالکام آگار
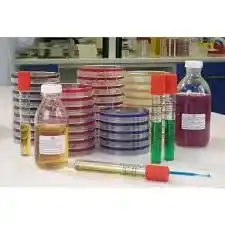
خرید محیط کشت پالکام آگار

اگر در آزمایشگاه میکروبیولوژی، کنترل کیفی مواد غذایی یا تحقیقات دانشگاهی با تشخیص لیستریا سروکار دارید، بدون اغراق PALCAM Agar یکی از محیطهای کشت کلیدی شماست. پالکام آگار دقیقاً برای همان جایی طراحی شده که تشخیص اشتباه، هزینهبر و حتی خطرناک است؛ یعنی صنایع غذایی، لبنیات، داروسازی و مراکز پژوهشی.
اگر شما یک دانشجو یا پژوهشگر دانشگاهی هستید، میتوانید محیط کشت پالکام اگار را با تضمین اصالت و بستهبندی استاندارد از فروشگاه ما تهیه کنید و پروژه تحقیقاتی خود را با اطمینان پیش ببرید.
این محصول با گرید تحقیقاتی و ارائه مستندات کامل COA و MSDS، انتخابی مطمئن برای پروژههای علمی و صنعتی است.

دانشجویان میکروبیولوژی و پژوهشگران خوب میدانند که لیستریا مونوسیتوژنز فقط یک باکتری ساده نیست؛ یک عامل بیماریزا با حساسیت بالا که نیاز به محیط کشت انتخابی و افتراقی استاندارد دارد. پالکام آگار با ترکیب مهندسیشده از مهارکنندهها و شاخصهای رنگی، این کار را با دقت بالا انجام میدهد.
در این صفحه، قرار نیست فقط تعریف کتابی بخوانید. هم مشخصات علمی پالکام آگار را بررسی میکنیم، هم کاربرد واقعی آن در آزمایشگاهها، هم تفاوت برندهای معتبر مثل Merck آلمان و Sigma-Aldrich را میگوییم و در نهایت، راهنمای خرید حرفهای برای انتخاب درست ارائه میدهیم.
خرید محیط کشت پالکام اگار برای دانشجویان، پژوهشگران و صنایع شیمیایی که به دنبال یک ماده آروماتیک هالوژنه با خلوص بالا هستند، اهمیت زیادی دارد.
ما اصالت کالا را تضمین میکنیم. محیط کشت پالکام اگار Merck/Sigma با برگه آنالیز (COA)، بستهبندی استاندارد و مشاوره تخصصی قابل ارائه است. هماکنون سفارش دهید.
برای خرید محیط کشت پالکام اگار با شیمی کهن در ارتباط باشید.
واتساپ: 09122885447 ( 24ساعت)
تعریف علمی و تحقیقاتی محیط کشت پالکام آگار
محیط کشت پالکام اگار PALCAM Agar یک محیط کشت انتخابی–افتراقی جامد است که بهطور اختصاصی برای جداسازی و شناسایی گونههای لیستریا بهویژه Listeria monocytogenes طراحی شده است. نام PALCAM از ترکیبات اصلی آن گرفته شده است: Polymyxin، Acriflavine، Lithium chloride، Ceftazidime، Aesculin و Mannitol.
مکانیزم عملکرد این محیط بهگونهای است که رشد اغلب باکتریهای مزاحم را مهار کرده و در عین حال، لیستریا را قادر میسازد با هیدرولیز اسکولین کلنیهایی با ظاهر مشخص (خاکستری–سبز با هاله تیره) ایجاد کند. وجود مانیتول نیز به افتراق لیستریا از سایر میکروارگانیسمها کمک میکند.
از نظر علمی، محیط کشت پالکام اگار یکی از محیطهای مرجع در استانداردهای ISO و روشهای رسمی کنترل کیفی مواد غذایی محسوب میشود. به همین دلیل در آزمایشگاههای دانشگاهی، صنایع غذایی و مراکز تحقیقاتی استفاده از آن یک انتخاب حرفهای و قابل استناد است.

ویژگیها و مشخصات فیزیکوشیمیایی PALCAM Agar
محیط کشت پالکام اگار دارای ویژگیهایی است که آن را از بسیاری از محیطهای معمولی متمایز میکند:
-
حالت فیزیکی: پودر خشک (Dehydrated Medium)
-
رنگ پودر: زرد مایل به قهوهای
-
pH نهایی: حدود 7.2 ± 0.2 در دمای 25 درجه سانتیگراد
-
حلالیت: قابل حل در آب مقطر با حرارت کنترلشده
-
قابلیت اتوکلاو: دارد (معمولاً 121°C به مدت 15 دقیقه)
ترکیبات مهارکننده مثل لیتیوم کلراید و پلیمیکسین باعث میشوند فلور مزاحم رشد نکند و محیط برای لیستریا کاملاً انتخابی باشد. همچنین وجود اسکولین و آهن منجر به واکنش رنگی قابل مشاهده در اطراف کلنیها میشود که کار تشخیص را سریعتر و مطمئنتر میکند.
این ویژگیها باعث شده محیط کشت پالکام اگار در محیطهای کاری شلوغ و نمونههای پیچیده مثل گوشت، لبنیات و غذاهای آماده عملکرد بسیار خوبی داشته باشد.
خواص شیمیایی و ایمنی محیط کشت پالکام آگار
از نظر شیمیایی، پالکام آگار یک محیط کنترلشده با ترکیبات مهارکننده فعال است. برخی از این ترکیبات (مانند آکریفلاوین) میتوانند در صورت تماس مستقیم با پوست یا استنشاق پودر، حساسیت ایجاد کنند؛ بنابراین رعایت اصول ایمنی آزمایشگاهی ضروری است.
نکات ایمنی مهم:
-
استفاده از دستکش، ماسک و عینک ایمنی هنگام وزنکشی
-
جلوگیری از استنشاق پودر محیط
-
دفع محیطهای استفادهشده طبق دستورالعمل پسماند زیستی
-
عدم تماس با مواد غذایی یا سطوح عمومی
در صورت رعایت این موارد، کار با پالکام آگار کاملاً ایمن و استاندارد خواهد بود و هیچ خطری برای کاربران حرفهای ایجاد نمیکند.

کاربردهای پالکام آگار در صنعت و تحقیقات آزمایشگاهی
شرکت شیمی کهن، نمایندگی مواد شیمیایی سیگماآلدریچ در ایران می باشد. این مجموعه کلیه محصولات و مواد شیمیایی آزمایشگاهی را از جمله محصولات مرک merck ، و سیگماآلدریچ ، و کلیه محصولات آزمایشگاهی و صنعتی را به مشتریان ارائه می دهد.
PALCAM Agar کاربردهای بسیار گستردهای دارد، از جمله:
-
کنترل کیفی صنایع غذایی (گوشت، لبنیات، غذاهای آماده)
-
آزمایشگاههای میکروبیولوژی دانشگاهی
-
تحقیقات اپیدمیولوژی و بهداشت مواد غذایی
-
آزمایشگاههای داروسازی و بیوتکنولوژی
-
پروژههای پایاننامه و مقالات علمی
در بسیاری از آزمایشگاهها، پالکام آگار مرحله کلیدی بعد از پیشغنیسازی نمونه است و نقش تعیینکنندهای در صحت نتایج دارد.
نحوه آمادهسازی و استفاده در آزمایشگاه
بهطور معمول:
-
مقدار مشخصی از پودر (طبق دستور برند) در آب مقطر حل میشود
-
محلول حرارت داده شده تا کاملاً شفاف شود
-
در اتوکلاو استریل میشود
-
پس از خنک شدن تا حدود 45–50 درجه، مکملها اضافه میشود
-
در پلیت ریخته و پس از جامد شدن استفاده میشود
کلنیهای لیستریا معمولاً پس از 24–48 ساعت انکوباسیون قابل مشاهده هستند.
با انتخاب این محصول، خیالتان از بابت اصالت کالا، کیفیت آزمایشگاهی و پشتیبانی علمی راحت است.
🔹 مناسب تحقیقات دانشگاهی و صنایع دارویی
🔹 گرید تحقیقاتی با خلوص بالا
🔹 تأمین از برندهای معتبر جهانی
🔹 ارسال سریع به سراسر کشور
👉 همین حالا استعلام قیمت بگیرید و سفارش خود را ثبت کنید
خریدی مطمئن برای نتایج دقیق آزمایشگاهی
مزایا و معایب PALCAM Agar
مزایا:
معایب:
برندهای معتبر و فرمهای بستهبندی
بستهبندیها معمولاً در وزنهای 100g، 500g و 1kg عرضه میشوند.

راهنمای خرید پالکام آگار
اگر مصرف دانشگاهی یا پایاننامه دارید، بستههای کوچک مناسبترند.
برای صنایع غذایی و آزمایشگاههای پرمصرف، بستههای بزرگ اقتصادیتر هستند.
حتماً به اصالت برند، تاریخ انقضا و شرایط نگهداری توجه کنید.
👉 برای خرید ۱-برومو-۴-فلوروبنزن اصل از Merck و Sigma-Aldrich همین حالا سفارش خود را ثبت کنید.
📦 تضمین اصالت | 🧪 گرید تحقیقاتی | 🚚 ارسال سریع به دانشگاه و شرکتها
سؤالات متداول (FAQ)
آیا محیط کشت پالکام اگار فقط برای لیستریا است؟
بله، طراحی آن اختصاصی برای لیستریا است.
تفاوت مرک و سیگما چیست؟
هر دو مرجعاند؛ انتخاب به سیاست آزمایشگاه و بودجه بستگی دارد.
خرید محیط کشت پالکام آگار اصل Merck و Sigma
اگر به دنبال نتیجه دقیق، تکرارپذیر و قابل استناد علمی هستید، پالکام آگار اصلی انتخاب حرفهای شماست.
📦 ارسال سریع | تضمین اصالت | مشاوره تخصصی قبل از خرید
👉 همین حالا سفارش دهید و با اطمینان آزمایش کنید

تضمین اصالت کالا
فروشگاه اینترنتی شیمیکهن این ماده را از برندهای معتبر تأمین میکند و شما میتوانید با شرایط زیر تهیه کنید:
-
خرید اینترنتی مطمئن و سریع
-
تضمین اصالت کالا و خلوص بالا
-
ارسال فوری به سراسر کشور
-
مشاوره تخصصی برای انتخاب محصول
-
نیاز به گواهی آنالیز و شماره کاتالوگ
-
ارسال با بستهبندی ایمن و حمل ویژه مواد شیمیایی
-
امکان خرید اینترنتی با مشاوره تخصصی و صدور فاکتور رسمی
-
خرید محیط کشت پالکام اگار مرک آلمان معمولاً نیازمند مجوزهای قانونی و نظارتی به دلیل خطرات بالقوه آن است.
- بستهبندی باید در ظروف مقاوم در برابر رطوبت و حرارت انجام شود.
- باید از تأمینکنندگان معتبر تهیه شود تا خلوص و کیفیت مناسب تضمین گردد.
برای خرید ۱-برومو-۴-فلوروبنزن مرک، کافیست با ما تماس بگیرید یا از طریق وبسایت، سفارش خود را ثبت کنید. ما آماده تأمین نمک همی (کلرید روی) آکریدین اورنج و محصولات دیگر از جمله آلومینیوم هیدروکسید کد 101091 مرک در هر مقدار موردنیاز شما هستیم.
📞 تماس با ما: [02166895887]
📧 ایمیل: [ info@shimikohan.ir]
🌐 سایت: [ww.shimikohan.ir]
همین حالا اقدام کنید خرید محیط کشت پالکام اگار مرک با کیفیت را با شرایط ویژه از ما تهیه کنید!
قیمت به عواملی مانند وزن، برند، نوع بستهبندی و حجم سفارش بستگی دارد. جهت دریافت قیمت بهروز با کارشناسان فروش تماس بگیرید یا از طریق فرم آنلاین سفارش دهید.
